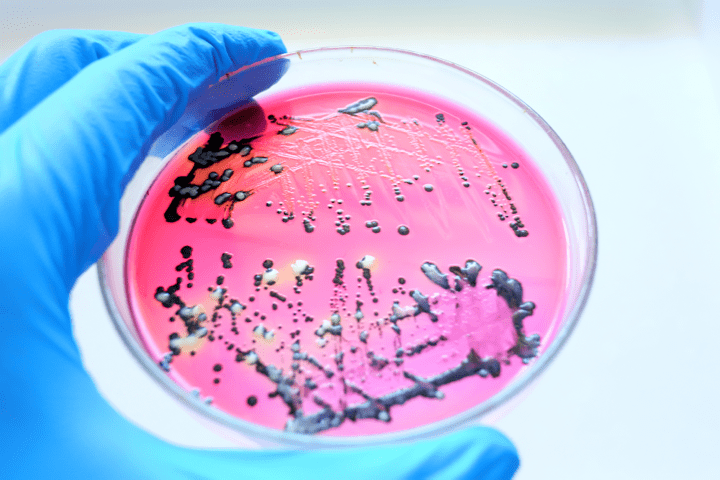
여름철 식중독 저리 갓! 제2탄 살모넬라

매거진 퍼즐
한 달에 한 번씩 찾아오는 그 녀석! PMS!
“왜 이렇게 허리랑 배가 아프지..?”
“설마.. 할 때가 됐나...?”
저에게는 한 달에 한 번씩 악몽이 찾아옵니다. 월경을 앞두고 날이 갈수록 심해지는 증상들 때문에 병원에 가봐야 하나 고민도 많이 되고 걱정이 늘어나는 요즘인데요. 이런 상황은 저뿐만이 아니라 많은 가임기 여성분들도 공감하실 거 같습니다. 이러한 증상들이 나타나는 것을 월경전증후군(PMS)이라고 한다는데요. 한 달에 한 번씩 고통을 주는 이 녀석, 어떻게 해야 될까요?

월경전증후군?
월경전증후군(PMS; Premenstrual Syndrome)이란 월경 전에 반복적으로 발생하는 정서적, 행동적, 신체적 증상들을 특징으로 하는 일련의 증상들이 나타나는 것을 말합니다. 월경전증후군에는 두 가지 중요한 특징이 있는데요. 하나는 이 증후군이 주기적으로 일어난다는 것이고, 다른 한 가지는 증상이 배란 후인 황체기에 일어난다는 점입니다. 미국 산부인과학회에서 월경전증후군은 월경전증후군의 정서 및 신체 증상이 최소 한 개 이상 있어야 하고, 월경 시작 전 5일 동안 이전의 3회 생리 주기에서 증상이 나타나야 하며, 생리 시작 후 4일 이내에 증상이 사라져야 하고, 향후 2-3회의 생리 주기에서 같은 모습이 반복되어야 한다고 정의합니다.
월경전증후군의 정확한 원인과 기전은 아직까지 확실하게 알려지지 않았는데요. 다만 호르몬의 불균형, 프로스타글란딘, 엔도르핀, 월경과 관련된 신념이나 태도 같은 정신적 요인, 영양이나 오염 같은 환경적 요인 등이 원인이 된다고 추정되고 있습니다. 의외로 많은 가임기 여성이 월경전증후군을 호소하고 있으며, 10명 중 적게는 2명 많게는 4.5명이 월경전 증후군을 경험하고 있습니다. 그리고 이들 중 약 10%는 일상생활에 지장을 받을 정도로 심한 월경전 증후군을 경험한다고 합니다.
월경전증후군의 증상?
월경전증후군의 다양한 증상은 월경주기 황체기 동안 나타나기 시작해 월경 2일 전 정도에 가장 심해지며, 월경 시작 후나 월경 후 1~3일에 증상이 소실된다고 알려져 있습니다. 월경전증후군의 경우 지금까지 알려진 증상이 150여 가지에 달할 정도로 다양하므로, 월경 전 일상생활이 불가능할 정도의 정신적, 신체적 증상이 나타나면 월경전증후군을 의심해 보고 치료를 시작하는 것이 좋습니다.
![17_4_mz_img_03.png 월경전증후군의 증상 - 신체적 증상 : 복부 팽창감 / 유방의 압통 또는 커짐 / 두통, 관절통 또는 근육통, 사지 부종, 체중 증가, 피로감 등 | 정신적 증상 : 분노 폭발, 불안 / 안절부절못함 / 당혹스러움 / 우울, 예민함, 사회적 위축(대인관계 회피) 등 [출처 : 한양대학교병원]](/upload/images/17_4_mz_img_03.png)
월경전증후군 증상 완화에 도움이 될 수 있는 방법은?
월경전증후군은 원인이 정확히 밝혀져 있지 않은 만큼 치료도 매우 다양합니다. 월경전증후군 증상 완화에 도움이 될 수 있는 식이요법과 생활습관을 안내해 드리겠습니다.
![17_4_mz_img_04.png 월경전증후군에 좋은 식이요법과 생활습관 : 달력에 월경 주기와 증상을 기록하여 미리 준비해보세요 / 알코올과 카페인 섭취는 피하고 소금과 당 섭취는 줄여보세요 / 일주일에 유산소 운동을 2~4회 이상 해보세요 / 생리 전후 가벼운 스트레칭과 스트레스 이완법이 도움이 될 수 있어요 [출처 : 박주현 강남세브란스병원 산부인과 교수, 한국일보]](/upload/images/17_4_mz_img_04.png)
여성들에게 있어 월경은 많은 불편함과 고통을 수반합니다. 무작정 참고 넘어가기보다는 월경 주기에 맞춰 증상이 있거나 점점 심해질 경우에는 병원에 내원하여 전문의의 도움을 받아 치료를 받아보시는 것을 권해드립니다.
[참고 자료]
1. 서울대학교병원 건강정보 (http://www.snuh.org/health/nMedInfo/nList.do)
2. 서울아산병원 질환백과 (https://www.amc.seoul.kr/asan/healthinfo/disease/diseaseSubmain.do)
3. 삼성서울병원 건강정보 (http://www.samsunghospital.com/home/healthInfo/main.do)
4. 한양대학교병원 건강정보 (https://www.hyumc.com/seoul/healthInfo/healthLife.do)
5. 박주현 강남세브란스병원 산부인과 교수. 강남세브란스병원과 함께 하는 건강 Tip] 월경전증후군. 한국일보. 2019.01.21 (https://www.hankookilbo.com/News/Read/201901191183063468)
마이퍼즐은 라이프스타일과 건강 상태를 꼼꼼하게 분석하여 당신에게 꼭 필요한 건강기능식품을 추천합니다.
글 뉴트리원 학술팀
* 본 컨텐츠의 저작권은 (주)뉴트리원에게 있습니다.